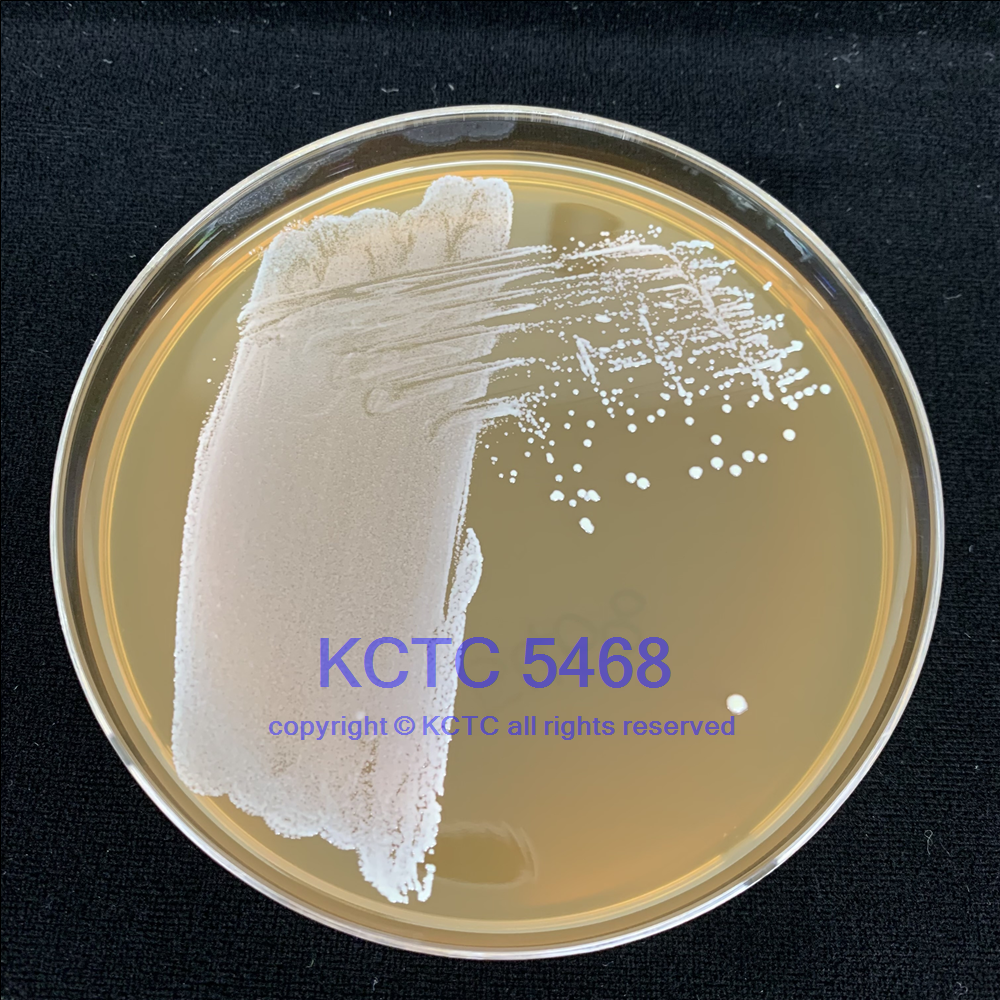

Lactobacillus fermentum Beijerinck 菌株拉丁名
(ATCC® 11976™) 菌株編號
Deposited As Lactobacillus acidophilus (Moro) Hansen and Mocquot
Strain Designations 菌株別名 NCIB 2797 [NCDO 394]
ATCC [11976], KCCM [40400], LMG [8900], NCFB [394], NCIMB [2797], NCTC [2797] ADD TO
KCTC 5468
Isolation 分離基物 Intestine of infant
Biosafety Level 生物安全等級 1
Biosafety classification is based on U.S. Public Health Service Guidelines, it is the responsibility of the customer to ensure that their facilities comply with biosafety regulations for their own country.
Product Format 提供形式 freeze-dried
Preceptrol® no
Type Strain 模式菌株 no
Medium 培養(yǎng)基 ATCC® Medium 416: Lactobacilli MRS Agar/Broth
Growth Conditions 生長條件
Temperature 培養(yǎng)溫度 : 37.0℃
Atmosphere 需氧情況 : Aerobic
Name of Depositor 寄存人 NCIMB
Chain of Custody 來源國家 ATCC <-- NCIMB <-- NCTC 2797 <-- R Cruickshank (Lactobacillus bifidus)
Isolation 分離基物 Intestine of infant
ATCC11976